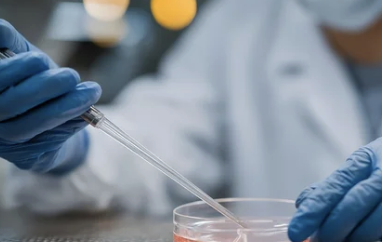

자격·절차·필요서류·유의사항 총정리
난임 부부가 아이를 갖기 위한 시술(인공수정·시험관아기 등)은
정서적으로나 경제적으로 큰 부담이 될 수 있습니다.
다행히도 우리나라는
정부와 지방자치단체 차원에서 난임부부 시술비 지원제도를 운영해
재정적 부담을 줄이고 있습니다.
이 글에서는
✔ 지원 대상과 자격
✔ 지원 가능한 시술 항목
✔ 신청 절차
✔ 필요 서류
✔ 유의사항
까지
한눈에 이해할 수 있도록 정리했습니다.
1. 난임부부 시술비 지원이란?



난임부부 시술비 지원은
아이를 갖고자 하는 부부가
경제적 이유로 치료를 망설이지 않도록
시술비 일부를 국가 또는 지자체가 도와주는 제도입니다.
주로
✔ 인공수정
✔ 시험관아기 시술(체외수정, ICSI 등)
✔ 배아 동결/해동
✔ 관련 검사 비용
를 포함하여 지원합니다.
지원금은
정부 지원 + 일부 지자체 지원이 결합된 형태로,
지역에 따라 세부 항목·지원 금액이 조금씩 다를 수 있습니다.
2. 지원 대상(자격 요건)
기본적으로 아래 요건을 모두 만족해야 합니다.
✔ ① 난임 판정이 있는 부부
난임은 보통 아래 기준으로 판정됩니다.
- 12개월 이상 피임 없이 생식 관찰했음에도 임신되지 않은 상태
(여성 나이가 높은 경우 6개월로 단축되는 경우도 있음)
이 판정은
산부인과 전문의 소견서 또는 검사 결과지로 확인됩니다.
✔ ② 국내 거주 및 건강보험 가입
- 대한민국 국민 또는 국내 체류 자격이 있는 외국인
- 건강보험 가입 또는 지역가입자
✔ ③ 소득·재산 기준
지원제도에 따라 소득 기준이 적용되는 경우도 있습니다.
예를 들어,
- 부부 연소득 ○○○○만 원 이하
- 보험료 기준 이하
이런 요건이 있는 경우도 있으므로
지원센터나 지자체 공고를 확인해야 합니다.
3. 지원 가능한 시술 항목



난임 시술비 지원은 주로 다음 항목을 포함합니다.
✔ 시술비
- 인공수정비
- 시험관아기 시술비
- ICSI(정자 직접주입)
✔ 보조생식시술 관련 검사
- 난관 체크
- 호르몬 검사
- 정액검사
✔ 배아 동결/해동 비용
동결 보관 기간 비용이나 해동 비용 일부를 지원하는 경우도 있습니다.
4. 지원 금액 및 횟수
지원 금액과 횟수는
정부와 지자체 정책에 따라 다르지만
다음과 같은 경향이 있습니다.
- 횟수 제한 (예: 지원 횟수 3회 이하)
- 금액 상한 (예: 회당 ○○만 원까지 지원)
- 연 단위 지원 가능
※ 정확한 금액·횟수는
건강보험공단 또는 거주지 지자체 공고를 확인해야 합니다.
5. 신청 절차

난임부부 시술비 지원 신청 절차는 다음과 같습니다.
① 의료기관 진단 및 소견서
먼저
산부인과에서 난임 판정을 받아야 합니다.
✔ 난임 진단서 또는 의사 소견서 제출
✔ 검사 결과지 확보
② 온라인 또는 오프라인 신청
지원 신청은 보통 두 가지 경로로 가능합니다.
✔ 온라인 신청
→ 보건복지부/건강보험공단 또는 지자체 포털
✔ 오프라인 신청
→ 주민센터/보건소 방문 접수
지역별로 지원센터가 별도로 운영되기도 하니
거주지 기준으로 확인하는 것이 안전합니다.
③ 서류 제출
필수 제출 서류는 다음과 같습니다.
- 신분증
- 가족관계증명서
- 난임 진단서/소견서
- 의료비 영수증
- 주민등록등본
- 건강보험 증빙서류
④ 심사 & 지원금 지급
제출된 서류를 통해
지원 자격 심사 후
지급이 결정됩니다.
지원금은 보통
✔ 계좌 이체
✔ 카드 환급 방식
로 지급됩니다.
6. 유의사항
⚠ 시술비 전액 지원 아님
대부분 “지원은 일부”이며
전액 지원이 아닌 경우가 많습니다.
예를 들면
총 시술비가 200만 원이라면
지원금으로 100만 원 지원되고
나머지는 본인 부담이 될 수 있습니다.
⚠ 지자체별 조건 상이
같은 난임비 지원이라도
서울, 부산, 경기, 인천 등 광역지자체마다
세부 항목과 금액이 다를 수 있습니다.
반드시
거주지 지자체 공고문을 확인하세요.
⚠ 지원 후 취소/변경 시 처리
지원을 받은 뒤
시술이 취소/변경될 때는
사전에 반드시 지원센터에 알려야 합니다.
무단 변경 시
지원금 환수 대상이 될 수 있습니다.
7. 꼭 알아야 할 현실 팁
✔ 지원 신청은 시술 전 또는 직후 신청이 유리
(일부는 사후 신청이 안 되는 경우가 있음)
✔ 진단서/검사 결과는 반드시 원본 확보
→ 복사본만으로는 심사 불리할 수 있음
✔ 지자체별 상담센터 전화 문의
→ 온라인 공고만으로 오해가 생길 수 있으니 상담 권장
마무리



난임부부 시술비 지원은
단순한 금전적 지원을 넘어
정서적 부담을 줄이고
시기를 놓치지 않도록 돕는 제도입니다.
하지만
지원 대상과 조건이 조금씩 다르고,
서류 준비와 심사 과정이 필요하기 때문에
사전에 충분한 확인과 준비가 필요합니다.
하루라도 빨리 정보를 알고 행동할수록
지원 받을 가능성은 높아집니다.
'알아두면 유용항 정보들' 카테고리의 다른 글
| 정수리 탈모 치료 완전정복 (0) | 2026.02.05 |
|---|---|
| 임플란트 비용, 시술 전 꼭 알아야 할 가격 구성과 절감 방법 총정리 (2) | 2025.07.29 |
| 손가락 관절염 종류, 특징과 차이점까지 한눈에 정리 (0) | 2025.05.28 |
| 스테로이드 연고, 효과와 부작용 총정리 – 꼭 써야 할까? 조심해야 할까? (2) | 2025.05.21 |
| 투룸 용달이사 비용, 짐 많은 소형 이사에 딱 맞는 가격표 총정리! (1) | 2025.05.21 |